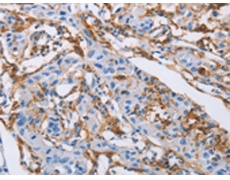
一抗

反應(yīng)種屬: Human
|
Background: |
The protein encoded by this gene is an inhibitory receptor found on peripheral mononuclear cells, including NK cells, T cells, and B cells. Inhibitory receptors regulate the immune response to prevent lysis of cells recognized as self. The gene is a member of both the immunoglobulin superfamily and the leukocyte-associated inhibitory receptor family. The gene maps to a region of 19q13.4 called the leukocyte receptor cluster, which contains at least 29 genes encoding leukocyte-expressed receptors of the immunoglobulin superfamily. |
|
Applications: |
ELISA, IHC |
|
Name of antibody: |
LAIR1 |
|
Immunogen: |
Fusion protein of human LAIR1 |
|
Full name: |
leukocyte-associated immunoglobulin-like receptor 1 |
|
Synonyms: |
CD305; LAIR-1 |
|
SwissProt: |
Q6GTX8 |
|
ELISA Recommended dilution: |
2000-5000 |
|
IHC positive control: |
Human lung cancer |
|
IHC Recommend dilution: |
25-100 |

 購物車
購物車 幫助
幫助
 021-54845833/15800441009
021-54845833/15800441009